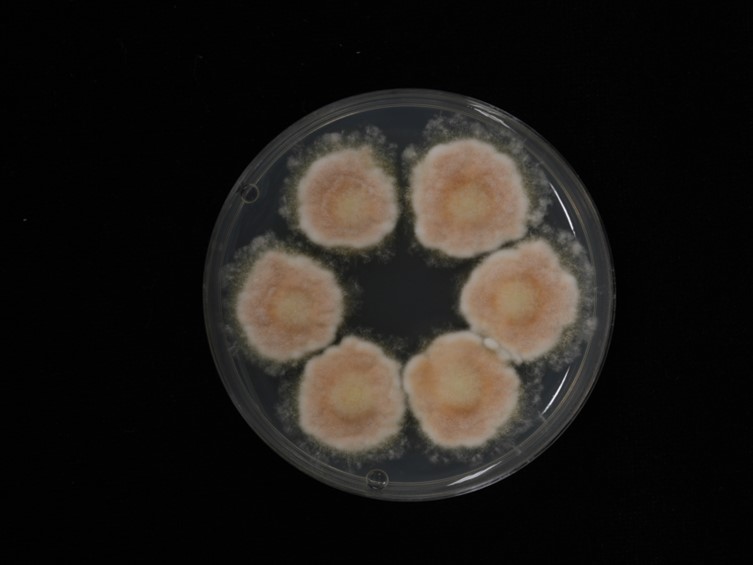

Holotype:
THAILAND, Chiang Mai Province, Kanlayaniwatthana District, 6 Oct. 2012, K. Tasanathai, W. Noisripoom, A. Khonsanit, R. Promharn, P. Srikitikulchai, holotype BBH 33739, ex-type living culture TBRC 7271.
Habitat:
Buried in soil, leaf litter.
Host:
Lepidopteran larva.
Description:
 Synnemata arising from the thorax and anus of the insect host (body size 15-25 × 5 mm). Synnemata erect, broad, irregularly branched starting 15-40 mm above the ground and continuously to the apex, 25-75 × 1-1.5 mm, orange. Isaria-like morph producing a mass of
Synnemata arising from the thorax and anus of the insect host (body size 15-25 × 5 mm). Synnemata erect, broad, irregularly branched starting 15-40 mm above the ground and continuously to the apex, 25-75 × 1-1.5 mm, orange. Isaria-like morph producing a mass of  conidia at the branches along the synnemata, powdery and floccose. Conidiophores biverticillate with
conidia at the branches along the synnemata, powdery and floccose. Conidiophores biverticillate with  phialides in whorls of two to seven, up to 150 μm long, 2-3 μm wide. Phialides 5-9 × 2-3 μm, with a cylindrical to ellipsoidal basal portion, tapering into a distinct neck, 1-3 × 1 μm. Conidia in chains, hyaline, fusiform, oval with pointed ends, smooth-walled, 1-celled, 2-3 × 1-2 μm.
phialides in whorls of two to seven, up to 150 μm long, 2-3 μm wide. Phialides 5-9 × 2-3 μm, with a cylindrical to ellipsoidal basal portion, tapering into a distinct neck, 1-3 × 1 μm. Conidia in chains, hyaline, fusiform, oval with pointed ends, smooth-walled, 1-celled, 2-3 × 1-2 μm.
Culture characteristics:
Colonies on PDA moderately fast-growing, ca 2.5 cm diam in 14 d at 25 °C, light orange, consisting of a basal felt and cottony, floccose over growth, reverse deep yellow. Prostrate hyphae smooth, septate, hyaline, 2–3 μm diam. Conidial structures consisting of erect conidiophores usually arising from the aerial hyphae, verticillate with phialides in whorls of two to four. Phialides 5–13 × 2–3 μm, with a cylindrical to ellipsoidal basal portion, tapering into a distinct neck, 2–4 × 1 μm. Conidia in chains, hyaline, fusiform, oval with pointed ends, 1-celled, 2–4 × 1–2 μm. Chlamydospores and synnemata not observed.
Colonies on PDA moderately fast-growing, ca 2.5 cm diam in 14 d at 25 °C, light orange, consisting of a basal felt and cottony, floccose over growth, reverse deep yellow. Prostrate hyphae smooth, septate, hyaline, 2–3 μm diam. Conidial structures consisting of erect conidiophores usually arising from the aerial hyphae, verticillate with phialides in whorls of two to four. Phialides 5–13 × 2–3 μm, with a cylindrical to ellipsoidal basal portion, tapering into a distinct neck, 2–4 × 1 μm. Conidia in chains, hyaline, fusiform, oval with pointed ends, 1-celled, 2–4 × 1–2 μm. Chlamydospores and synnemata not observed.
Reference:
Mongkolsamrit S, Noisripooma W, Thanakitpipattana D, et al. (2018). Disentangling cryptic species with isaria-like morphs in Cordycipitaceae. Mycologia 110: 230–257.
DOI: https://doi.org/10.1080/00275514.2018.1446651Species |
Strain |
Compound |
Pubchem CID |
Biological activity |
Reference |
|---|
|
Strain |
ITS | LSU | RPB1 | RPB2 | TEF1 |
|---|---|---|---|---|---|
| TBRC 7271 | MF140764 | MF140728 | MF140791 | MF140818 | MF140846 |
| TBRC 7272 | MF140763 | MF140727 | MF140817 | MF140845 | |
| TBRC 7273 | MF140762 | MF140726 | MF140816 | MF140844 |